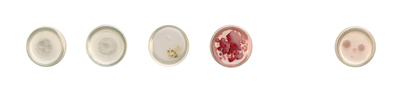

| Mon | Tue | Wed | Thu | Fri | Sat | Sun | April,05 | 01kaneko | 02 | 03 | 04 × | 05 × | 06 × | 07 × | 08 × | 09 × | 10 × | 11 × | 12 × | 13 × | 14 × | 15 × | 16 AZUMA | 17 | 18 × | 19 | 20 | 21 | 22 | 23 | 24 | 25 × | 26 | 27 | 28 | 29 | 30 |
| Mon | Tue | Wed | Thu | Fri | Sat | Sun | May,05 | 01 | 02 × | 03 | 04 | 05 | 06 | 07 | 08 | 09 × | 10 × | 11 × | 12 × | 13 × | 14 MORIMOTO | 15 | 16 × | 17 | 18 | 19 | 20 | 21 | 22 | 23 × | 24 | 25 | 26 | 27 | 28 | 29 | 30 × | 31 |
| June,05 | 01 | 02 | 03 | 04 | 05 | 06 × | 07 × | 08 × | 09 × | 10 × | 11 SAKAMOTO | 12 | 13 × | 14 | 15 | 16 | 17 | 18 | 19 | 2 × | 21 | 22 | 23 | 24 | 25 | 26 | 27 × | 28 | 29 | 30 |
| Mon | Tue | Wed | Thu | Fri | Sat | Sun | July,05 | 01 | 02 | 03 | 04 × | 05 × | 06 × | 07 × | 08 × | 09MIKI | 10 | 11 × | 12 | 13 | 14 | 15 | 16 | 17 | 18 × | 19 | 20 | 21 | 22 | 23 | 24 × | 25 × | 26INOUE | 27 | 28 | 29 | 30 | 31 |
| Mon | Tue | Wed | Thu | Fri | Sat | Sun |
| August | 02 | 03 | 04 | 05 | 06 | 07 | 08 × | 09 AKAMATSU MATSUNAGA |
10 | 11 | 12 | 13 | 14 | 15 × | 16 × | 17 × | 18 × | 19 × | 20 × | 21 × | 22 × | 23ASANO | 24 | 25 | 26 | 27 | 28 | 29 × | 30INUKAI OHTAKI |
31 |
| September | 01 | 02 | 03 | 04 | 05 × | 06YAMADA | 07 | 08 | 09 | 10 | 11 | 12 × | 13NAKADE | 14 | 15 | 16 | 17 | 18 | 19 × | 20NAKATSUKA | 21 | 22 | 23 | 24 | 25 | 26 × | 27 | 28 | 29 | 30 | 31 |
AZUMA,Yoshitaka " Lie and secret ant lion " : painting
16 April - 08 May, 2005
*hours : 13-20:00,closed on Mondays
東義孝個展「嘘および秘密アリ地獄」絵画
2005年4月16日(土)ー5月8日(日)
※開廊時間:午後1−8時
※定休日:月曜
現在、KYOTO ART MAP 合同展「裏・アートマップ」に出展した作品もギャラリーでご覧いただけます。
photo by N.Kawada
◎森本絵利 展 絵画・立体
2005年5月14日(土)〜6月5日(日) ※開廊時間:午後1−8時/定休日:月曜
MORIMOTO,Eri: painting,etc.
14 May - 05 June, 2005
*hours : 13-20:00,closed on Mondays back to calender
2003年神戸アートアニュアル、 2004年水戸芸術館現代美術センター<クリテリオム>、 TAMAVIVANT、2005年京都府美術工芸新鋭選抜展において、「はさみで紙を切る」記録映像とその行為から生まれた紙片を提示した。
今回は、切る(1点)・描く(9点)・編む(2点)の3種の作品により構成。
写真左(左から);
"waterline #red" (パネルにアクリル絵具・50×50cm・2005年)
"outline #1" (パネルにアクリル絵具・50×50cm・2005年)
"waterline #blue" (パネルにアクリル絵具・50×50cm・2005年)
"outline #3" (パネルにアクリル絵具・50×50cm・2005年)
写真右(左から);
”percolation - paper mountains” (紙:チラシ・2004〜5年)
"percolator - 「笊」" (紙テープ、アクリルラッカー・2005年)
"contour map #white" (パネルにアクリル絵具、油絵具・50×50cm・2005年)
"outline #4" (パネルにアクリル絵具・50×50cm・2005年)
”percolation - paper mountains” (部分)
◎坂本優子個展「clouds and mountain」絵画・ドローイング
2005年6月11日(土)〜7月3日(日) ※開廊時間:午後1−8時/定休日:月曜
SAKAMOTO,Yuko " clouds and mountain " : painting and drawing
11 June - 03 July, 2005
*hours : 13-20:00,closed on Mondays back to calender
" a road "2005
◎三木陽子個展「TUBE - live and let live」陶によるインスタレーション
2005年7月9日(土)〜23日(土) ※開廊時間:午後1−8時/定休日:月曜
MIKI,Yoko " TUBE-live and let live " : installation of ceramics
09 - 23 July, 2005
*hours : 13-20:00,closed on Mondays back to calender
◎井上リリー写真展「Virginity」
2005年7月26日(火)〜8月7日(日) ※開廊時間:午後1−8時/定休日:月曜
Riri Inoue photo show in Kyoto " Virginity "
26 July - 07 August, 2005
*hours : 13-20:00,closed on Mondays back to calender
2005
◎夏の連続展★ヴォイスギャラリーの第4世代
19年目を迎えたヴォイスギャラリー最若手アーティストたち5組が連続して個展、グループ展を行います。
vol.1
赤松規子・松永紗耶加展「空想空気」インスタレーション
2005年8月9日(火)〜14日(日) ※開廊時間:午後1−8時/最終日は午後7時まで
"youngest artists in voice gallery" vol.1 AKAMATSU,Noriko & MATSUNAGA,Sayaka / installation
09 - 14 August, 2005 / *hours : 13-20:00 back to calender
赤松・松永は、この春京都造形芸術大学空間演出デザイン学科空間デザインコース卒業。
自分の中で・他者との間で繰り返される情報の無意識の変換、あるいは意図的な変換を各々の作風によってオブジェ化し、空間を構成。
出展予定作品:左/赤松規子「エロス1.2.3」 右/松永紗耶加「R.....'s cube」
vol.2
浅野幸生個展 ”a much too sunshiny day"インスタレーション
2005年8月23日(火)〜28日(日) ※開廊時間:午後1−8時/最終日は午後7時まで
"youngest artists in voice gallery" vol.2 ASANO,Yukio ”a much too sunshiny day" / installation
23 - 28 August, 2005 / *hours : 13-20:00 back to calender
成安造形大学構想表現造形美術科造形表現群構想表現クラス4回生。
これまでに廃車のライトでつくった「点滅するスーツ」など、行動や身体への関心を作品化。
新作のためのドローイング
vol.3
犬飼千絵・大瀧加与展「不穏」 平面
2005年8月30日(火)〜9月4日(日) ※開廊時間:午後1−8時/最終日は午後7時まで
後援:名古屋芸術大学
"youngest artists in voice gallery" vol.3 INUKAI,Chie & OHTAKI,Kayo / graphic arts
23 - 28 August, 2005 / *hours : 13-20:00 back to calender
犬飼・大瀧とも、名古屋芸術大学大学院に在学中。
「<不穏>とは、穏やかでないもの危険をはらんでいることを表す言葉だ。今回の展示では、世の中の不穏な状況、人物、モノと各々の持つ内面や世界観をリンクさせ、表現した作品が中心になる。作品に描かれるのは、未来や過去の出来事、近しい人物や空想の情景だ。また、大瀧、犬飼は、それぞれの表現方法は違っていても、根底には<不穏>なものに反応するという意識の共通部分がある。不穏という共通項を見つけた私達の二人展、是非ご覧下さい。」(犬飼・大瀧)
左/犬飼千絵作品 右/大瀧加与作品
vol.4
山田卓矢個展「穴の為の素描と物」 平面・立体
2005年9月6日(火)〜11日(日) ※開廊時間:午後1−8時/最終日は午後7時まで
"youngest artists in voice gallery" vol.4 YAMADA,Takuya / graphical works and object
06 - 11 September, 2005 / *hours : 13-20:00 back to calender
京都造形芸術大学大学院芸術表現専攻。
「モノがない故に表出する暗」=穴と、穴の表現を取り巻く事物や要素の関係性への関心をテーマとする。
vol.5
中出陽子個展 インスタレーション
2005年9月13日(火)〜18日(日) ※開廊時間:午後1−8時/最終日は午後7時まで
"youngest artists in voice gallery" vol.5 NAKADE,Yoko / installation
13 - 18 September, 2005 / *hours : 13-20:00 back to calender
成安造形大学彫刻研究生。
環境や空間の条件に思索を関連づけ、作品としての行為やインスタレーションを制作する。
◎中塚智個展 「蘇生装置としての美術-revival device-」版画
2005年9月20日(火)〜10月2日(日) ※開廊時間:午後1−8時・最終日午後7時まで/定休日:月曜
NAKATSUKA,Satoshi "revival device" print work
20 September - 02 October, 2005
*hours : 13-20:00,closed on Mondays back to calender
京都精華大学大学院在学。インクジェット出力やシルクスクリーンによる。シャーレ10点を用いた立体的な表現と転写平面数点により構成。
シャーレ内にイメージを浮かびあがせる作品では、「水転写」を用いる。
「これまで身近な死が制作の動機になっています。次第に消えていくもの・突如として深い闇に消えていくものにもう一度出逢いたいと考えていました。
あらかじめイメージが壊れるようにしたり、またイメージを完成させそれをまた始まりの状態に戻しもう一度掘り起こしていく。その行程は
いずれにしても捉え様のない記憶の断片を繕おうとしていく事、その方法を探っていたのだと考えています。そこからゴースト(それは既
に世界に存在しないモノ達)に肉体を与える。実現化し現実味を帯び始める瞬間を再現してきました。
今回の展覧会では、この世界に既に存在しないモノ達を蘇生させる為の実践の場だと考えています。」(中塚)
*水転写;
紙に水溶性バインダーをコートした専用転写紙にインク及びカバーコートを印刷してあります。それを水に浮かべ立体物を引き上 げ水溶性バインダーが溶けインクを印刷するのがスタンダードです。
中塚の場合はオブラートにイメージを刷り水に浮かべインクは耐水性なので溶けきらずオブラートだけ水に溶けイメージだけ水面に残ります。
*転写作品;
インクジェットプリンター(顔料系)から印刷された用紙に下地用の絵具(ジェッソ)を置きその絵具が乾燥と同時にインクを 吸い上げます。それを引き剥がすと反転したイメージがその絵具に写ります。
▲TOP ▲Back to Scedules